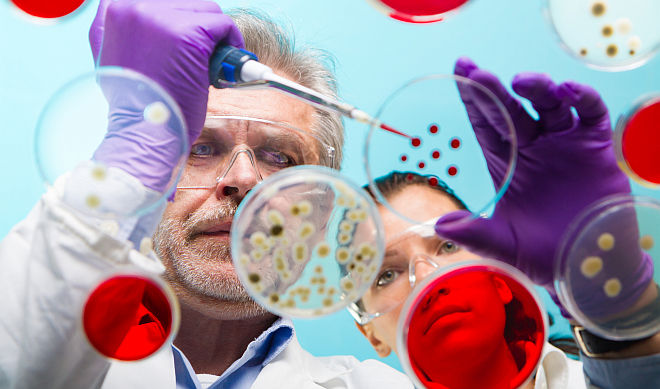

Ve čtvrtek 15. prosince převzali Cenu ministra zdravotnictví za mimořádné výsledky ve zdravotnickém výzkumu a vývoji řešitelé projektů, které byly podporovány Interní grantovou agenturou Ministerstva zdravotnictví z veřejných zdrojů. Nechyběly mezi nimi i týmy Univerzity Karlovy.
Vědecký tým pod vedením doc. ing. Stanislava Kmocha, CSc., z Ústavu dědičných metabolických poruch 1. LF UK a Všeobecné fakultní nemocnice v Praze dostal cenu za zkoumání genetických a molekulárních příčin vzácných nemocí. Provedl více než 40 studií zaměřených na hledání genetických a molekulárních příčin vzácných nemocí. Díky novým metodám analýzy genomu (souboru veškeré genetické informace konkrétního organismu) dokázali vědci určit příčinu více než 20 vzácných geneticky podmíněných onemocnění.
„Výzkum přinesl nové poznatky o funkci genů zapříčiňujících onemocnění a o mechanismech vzniku a rozvoje studovaných nemocí. Získané informace jsme využili již v rámci řešení projektu k cílené DNA diagnostice, kvalifikovanému genetickému poradenství, prenatální diagnostice a prevenci. Nové poznatky se rovněž staly východiskem pro vývoj cílené léčby,“ uvedl doc. Kmoch. Doplnil, že se na výzkumu dále podíleli Mgr. Viktor Stránecký, Ph.D., Mgr. Hana Hartmannová, Ph.D., Ing. Kateřina Hodaňová, PhD., MUDr. Helena Hůlková, Ph.D., všichni z 1. lékařské fakulty UK.
Další tým v čele s prof. MUDr. Robertem Jechem, Ph.D., z Neurologické kliniky 1. LF UK a VFN zkoumal problematiku léčby těžkých dystonií pomocí hluboké mozkové stimulace (Deep Brain Stimulation – DBS). Dystonie se projevuje přetrvávajícími svalovými křečemi a zkroucením částí těla. Končetiny, trup a šíje se samy pohybují a zaujímají pozice zcela nezávisle na vůli nemocného. Nemoc je natolik závažná, že často vede až k invalidizaci pacienta.
Hluboká mozková stimulace se používá k léčbě dystonií tehdy, kdy podávané léky nezabírají nebo nepřinášejí pacientovi dostatečnou úlevu. „Metoda spočívá v tom, že se do určitých částí mozku – bazálních ganglií – zavede elektroda spojená s programovatelným stimulátorem uloženým pod kůží na hrudníku. Elektrické pulsy vysílané stimulátorem dokážou natolik ovlivňovat činnost mozku, že se postupně ‚přeprogramuje’. Po několika týdnech až měsících dystonické křeče povolí a pacient získá zpět nad řízením svých pohybů dostatečnou kontrolu,“ vysvětlil prof. Jech.
Tým pomocí zobrazovacích a neurofyziologických metod zjistil, co se přesně v mozku těchto nemocných děje. Pomocí funkční magnetické rezonance zdokumentoval, že se zapojení a způsob komunikace mezi mozkovou kůrou a hlubokými centry díky této léčbě mění, takže nakonec připomíná zapojení mozku u zdravých lidí. Dále zjistil, že se mozková kůra vlivem stimulace stává méně dráždivou, což pacientům umožňuje dystonické pohyby lépe potlačit.
„Výzkumný projekt zpřesnil požadavky na umístění mozkové elektrody a kritéria výběru pacientů, podle nichž bude možné budoucí efekt léčby lépe odhadnout,“ doplnil prof. Jech. Dodal, že na výzkumu se podíleli MUDr. Anna Fečíková z 1. LF UK a VFN a odborníci z dalších institucí – prof. MUDr. Ivana Štětkářová, CSc., a MUDr. Dušan Urgošík, CSc.
Na slavnostním setkání v Lobkowiczkém paláci, které se tradičně koná v blízkosti termínu výročí narození Jana Evangelisty Purkyně (17. prosince), byla udělena také pětice čestných uznání. I zde dvě ocenění směřovala na Univerzitu Karlovu, konkrétně k doc. Ing. Jaroslavu Hrabákovi, Ph.D., z Lékařské fakulty Univerzity Karlovy v Plzni za projekt Analýza mobilních genetických elementů nesoucích geny metalo-beta-laktamáz v České republice a k prof. RNDr. Jarmile Vinšové, CSc., z Farmaceutické fakulty Univerzity Karlovy v Hradci Králové za projekt Design a enzymové cílení nových antibakteriálně účinných sloučenin vůči multilékově rezistentním kmenům.